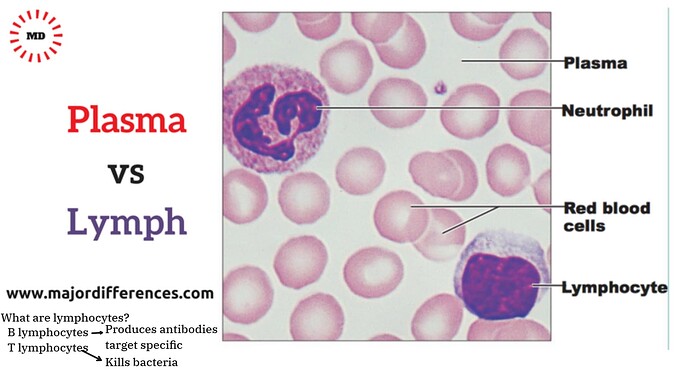
Presentation__2025-12-22T16_01_45.295Z

CUBE ChatShaala | 22 December 2025
CUBE ChatShaala | 22 December 2025
Theme: From Everyday Observations to the Language of Immunology
 Key Discussion
Key Discussion
The ChatShaala session progressed through a carefully connected set of biological ideas, moving from familiar organisms to foundational concepts in immunology and laboratory practice. The discussion opened with brief references to commonly encountered biological examples—mosquito species, fruit flies, curd microbes, and potato nematodes—used to anchor scientific thinking in daily life.
The core focus of the session was immunology, with special attention to the lymphatic system. Lymph nodes were introduced as strategic biological checkpoints rather than passive structures. The concept of lymph was clarified as a fluid derived from plasma, distinct from blood due to the absence of red blood cells and platelets, yet rich in lymphocytes.
Blood composition was systematically reviewed: plasma as the fluid matrix, red blood cells for transport, white blood cells for defense, and platelets for clotting. A key biochemical distinction between plasma and serum was highlighted, emphasizing that serum lacks clotting factors.
Microscopic understanding was strengthened through discussion of blood smear experiments, including the use of methanol as a fixative and stains such as Giemsa and methylene blue to differentiate cellular components. Immune mechanisms like phagocytosis and the functional contrast between antigens and antibodies were explained, with emphasis on the role of B cells in antibody production.
Overall, the session balanced conceptual clarity with experimental relevance, reinforcing how invisible cellular processes shape visible health outcomes.
 Provocative Discussion Questions
Provocative Discussion Questions
-
If lymph isn’t blood, why does your body depend on it so deeply?
-
Do swollen lymph nodes signal weakness—or a war being won?
-
How much biology can a single smear on a glass slide reveal?
-
Is immunity about attack, defense, or recognition?
-
What disappears from blood to turn plasma into serum?
What I Learned Today
-
Lymph is not just a leftover fluid but a crucial medium for immune surveillance.
-
Lymphocytes are specialized white blood cells with targeted roles, not generic defenders.
-
Plasma and serum differ in function because of clotting factors, not because of cells.
-
Simple laboratory techniques like blood smears translate abstract theory into visible evidence.
-
Immunology connects structure, chemistry, and function seamlessly.
 TINKE Moments (This I Never Knew Earlier)
TINKE Moments (This I Never Knew Earlier)
-
Lymph originates from plasma but follows a completely different functional pathway.
-
Lymph nodes actively filter and assess biological threats rather than merely storing cells.
-
Methanol’s role in blood smears is preservation, not staining.
-
B cells do not “fight” directly but produce molecular tools that do the fighting.
-
Phagocytosis is both a cleanup process and a trigger for adaptive immunity.
 Gaps and Misconceptions
Gaps and Misconceptions
-
Confusing lymph with blood due to their shared origin in plasma.
-
Assuming all white blood cells perform the same immune function.
-
Believing serum and plasma are interchangeable terms.
-
Underestimating how much preparation affects microscopic observations.
-
Viewing immunity as a single response rather than a coordinated system.